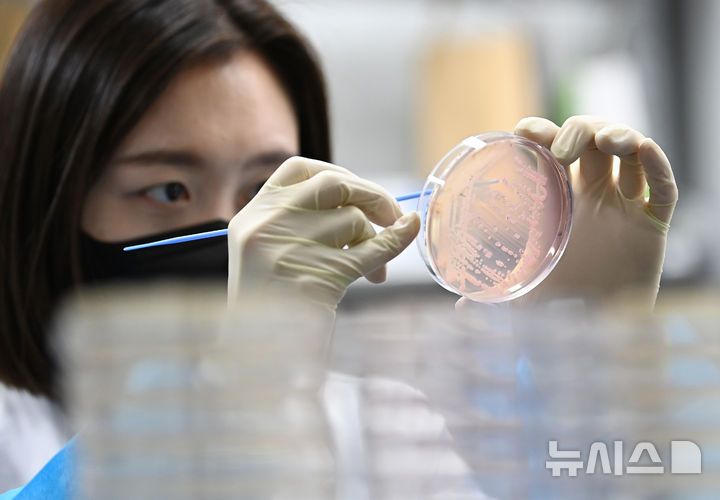

“비 많은 가을, 곰팡이독소 비상”…곡류·견과류 안전기준 경보
10월 강우가 이어지며 곡류와 견과류 등 식품에서 곰팡이 독소 오염 위험이 급증하고 있다. 최근 식품안전업계는 연이은 비와 높은 습도가 식품 보관에 악조건이 된다는 점에 주목하며, 특히 곡류·두류 등에 서식하는 곰팡이의 아플라톡신 등 독소 생성 가능성을 경고하고 있다. 업계는 이번 상황을 식품 곰팡이독소 관리의 분기점으로 평가한다.
식품 곰팡이독소는 곰팡이가 고온다습한 환경에서 번식할 때 생성된다. 대표적인 성분인 아플라톡신 B1은 국제암연구소가 발암물질로 지정했으며, 268도에서도 분해되지 않아 일반적인 가열이나 조리 과정으로 제거되지 않는다. 이외에도 파튤린, 오크라톡신 등 다양한 곰팡이독소가 확인되고 있는데, 곡류나 견과류, 두류 등 주로 수분과 온도가 적정한 조건에서 많이 생긴다.
기술적으로 곰팡이 성장과 독소 생성은 수분함량이 20~25%, 상대습도가 70~90%, 온도 22~30도에서 크게 증가한다. 따라서 가정이나 산업 현장에서는 습도 60% 이하, 온도 10~15도 이하에서 최대한 온도 변화가 적은 곳에 보관하는 것이 독소 예방의 기본으로 지목된다. 또한 벌레에 의해 손상된 곡물이나 개봉 후 보관 중인 견과류는 알갱이를 제거하고 밀봉해야 하며, 곡물 껍질을 벗기기보다는 껍질 채 보관하는 것이 안전하다는 설명이다.
시장에서는 곰팡이독소 오염에 따른 실제 피해 가능성도 거론된다. 곰팡이가 피었거나 냄새·색깔이 변한 식품은 겉으로만 판단해 일부 도려내도, 독소가 내부에 이미 퍼져 있을 수 있다. 특히 생강이나 쌀처럼 조직 사이 독소 확산이 빠른 품목은 위험성이 높아 오염이 의심될 경우 섭취를 피하는 것이 최선이다. 아울러 세척·가열 등 일반적 방식을 거쳐도 독소는 대부분 남는다.
해외 식품위생기준에서도 곰팡이독소는 주요 관리대상이다. 미국 FDA, EU 식품안전청 등은 아플라톡신 등 곰팡이독소의 기준치를 엄격히 두고 있으며, 식재료 침수나 변질 식품은 일괄 폐기하도록 하고 있다. 우리나라도 식약처에서 독소 기준 및 위생 가이드라인을 제시 중이다.
산업계와 전문가들은 우기 등 습도 관리가 쉽지 않은 환경에서는 실내 제습기나 에어컨 가동, 식품 전용 소독·건조 등 선제적 대응이 핵심이라고 짚는다. “가열이나 세척만으로 곰팡이독소를 제거하는 것은 불가능에 가깝다”며, “보관 환경의 기술적·시스템적 개선이 안전 확보의 결정적 변수”라는 의견이 제시되고 있다.
식품 안전 산업에서는 곰팡이독소 방지 시스템, 사물인터넷 기반 실내환경 모니터링 등 IT기술 접목도 주목된다. “이번 가을 습도 이슈는 곰팡이독소 관리 패러다임을 재점검하는 계기로 작용할 전망이다”라는 지적도 나온다. 산업계는 이번 강수기 이후 곰팡이독소로 인한 시장 혼란을 최소화할 수 있을지 예의주시하고 있다.

